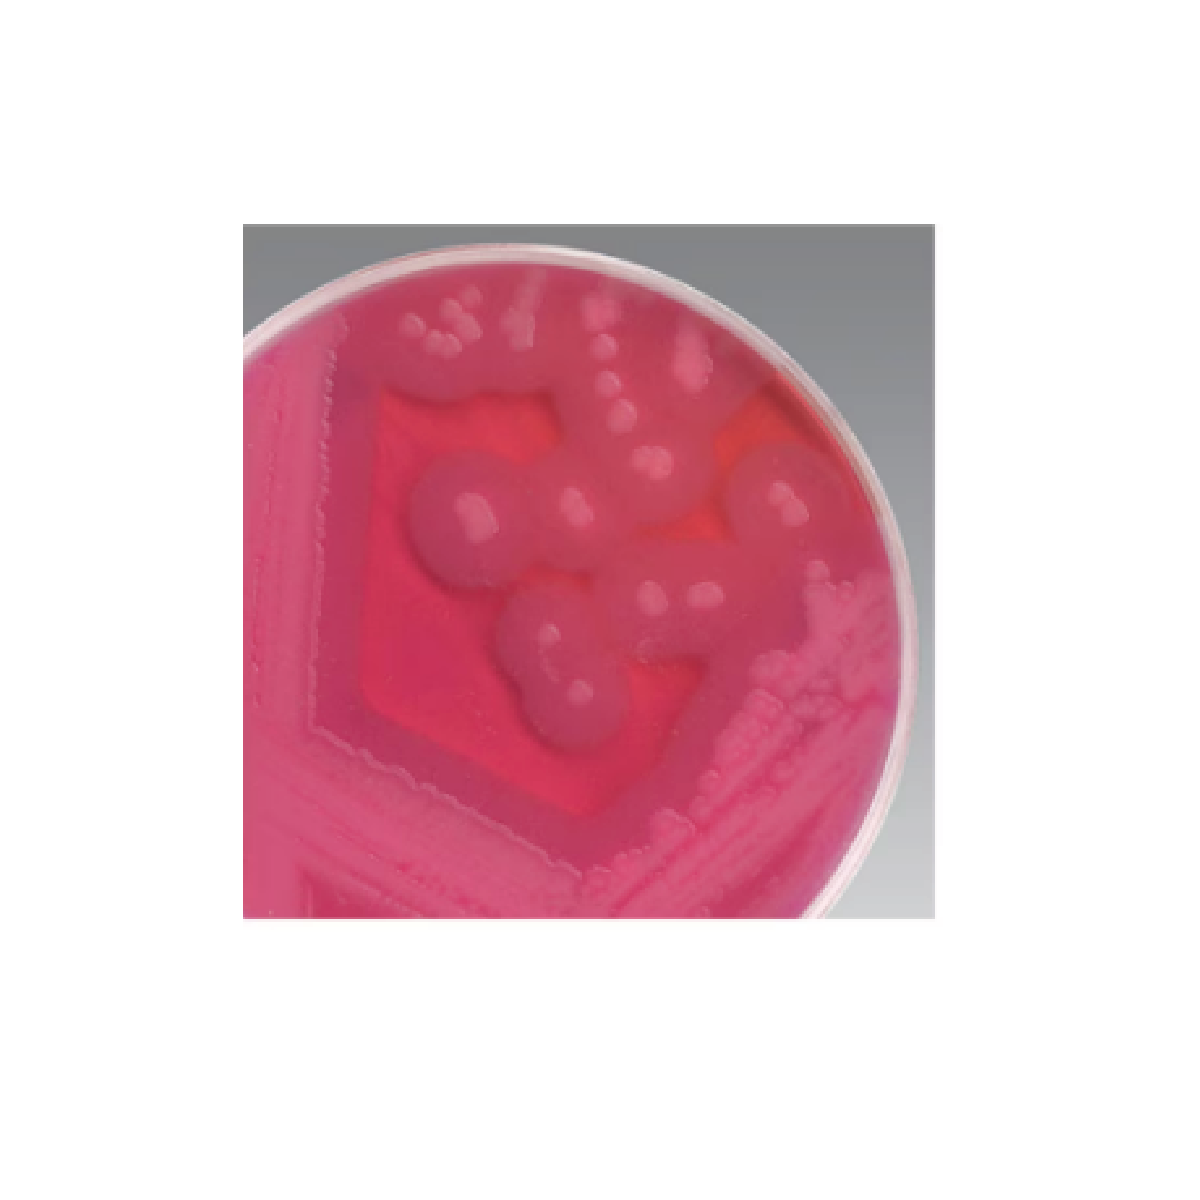
MYP Agar (Dehydrated) / Agar PAI (deshidratado)

MYP Agar (Dehydrated) / Agar PAI (deshidratado)
Enumere Bacillus cereus en muestras de alimentos con medio selectivo y diferencial Thermo Scientific™ Oxoid™ MYP Agar (deshidratado). Las características diagnósticas del medio dependen de que Bacillus cereus no utilice manitol y de la capacidad de la mayoría de las cepas para producir fosfolipasa C, lo que da como resultado un halo opaco alrededor de las colonias.